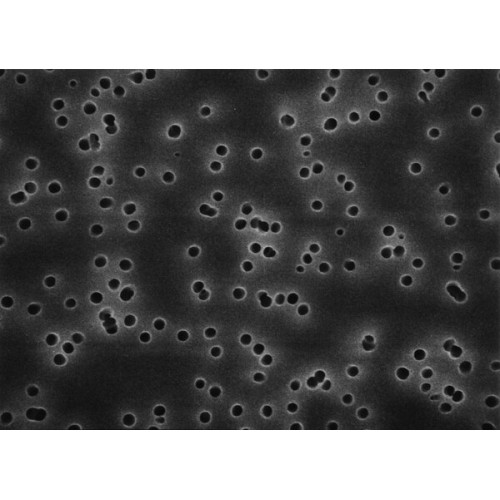
MEMBRANA FILTRAÇÃO POLICARBONATO ISOPORE DIAM. 47mm PORO 3um MILLIPORE (CX C/ 100 UND) MEMBRANA FILTRAÇÃO POLICARBONATO ISOPORE DIAM. 47mm PORO 3um MILLIPORE (CX C/ 100 UND)

MEMBRANA FILTRAÇÃO POLICARBONATO ISOPORE DIAM. 47mm PORO 3um MILLIPORE (CX C/ 100 UND)
Modelo: TSTP04700
-
R$1.091,02
ou até 3x de R$363,67 sem juros
Economize 5% no PIX: R$1.036,47
ou 3.5% no boleto: R$1.052,83
Descrição
Informações fisico-químicas:
Índice de refração: 1.6
Tamanho dos poros: 3.0 µm
Vazão do ar: 0.868 L/min x cm²/psi
Ponto de bolha a 23 °C: ?0.43 bar, air with water
Extraíveis gravimétricos (%): < 1%
Porosidade %: 11.3%
Vazão da água: - Avg. 475 mL/min x cm² (typical results at 10 psi)
- 3628 mL/min x cm²/psi
Dimensões:
Superfície do filtro: Liso
Espessura: 22 µm
Diâmetro do filtro (?): 47 mm
Informação sobre materiais
Química: Polycarbonate
Índice de refração: 1.6
Tamanho dos poros: 3.0 µm
Vazão do ar: 0.868 L/min x cm²/psi
Ponto de bolha a 23 °C: ?0.43 bar, air with water
Extraíveis gravimétricos (%): < 1%
Porosidade %: 11.3%
Vazão da água: - Avg. 475 mL/min x cm² (typical results at 10 psi)
- 3628 mL/min x cm²/psi
Dimensões:
Superfície do filtro: Liso
Espessura: 22 µm
Diâmetro do filtro (?): 47 mm
Informação sobre materiais
Química: Polycarbonate